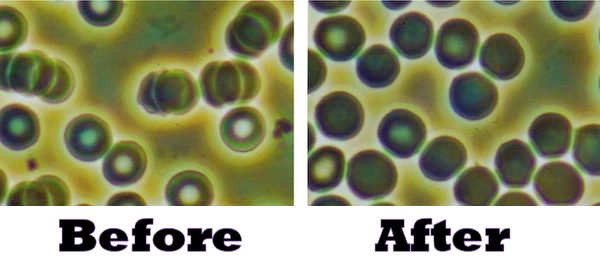

Double Helix Water
- Double Helix Water is a new, high-tech supplement in the category known as energy medicine.
- Is a significant breakthrough in restoring human function to its optimum capabilities by enabling energy to flow correctly through the body and its myriad of cells.
- It repairs the body's Chi (Qi) pathways just by drinking or rubbing on the skin.
- It helps inflammatory hot spots in the body to diminish by assisting inflammatory energy to flow away correctly.
- And it helps soft-tissue pain resulting from those inflammatory hot spots to be rapidly alleviated.
- The Double Helix Water supplement consists of polar charged, double helix, solid-state-at-room-temperature, water molecules suspended in highly purified water.
- These molecules are believed to be the substance ("wiring") of which the subtle energy grid (meridians) of the human body is comprised.
- It is also believed that these molecules enable subtle energy flow into and out of cells... creating balance among the cells of the body.
- In other words, it is believed that this new phase of water (solid state at room temperature lines up (because of its polar charges to form conduits along which subtle energy travels.
- Chinese healers have long believed in this meridians, or channels of energy, while Western scientists scoff because they were invisible to western methods of detection, until discovered via Atomic Force Microscopes. Only with the advent of Atomic Force microscopes and incredible perseverance could they be discovered.
Double Helix Water and its Effect on the Subtle Energy Circuity of the Human Body
Double-Helix Water™ is the result of intensive studies during the last 15 years into the peculiar properties of highly charged, polar, solid-state water particles and their effect upon the electrical circuitry within the body called meridians.
Eastern medicine believes that correcting the flow of energy through the meridian pathways is vital to having optimum wellness, and in overcoming injuries, pain, inflammation and lowered function in any part of the body. Double Helix Water is now the fastest and simplest way to heal the body’s meridians.

The inventors of Double Helix Water, David L. Gann and Shui-yin Lo, have written a fascinating book about this discovery and why they believe that Double Helix water is the substance of which the energy matrix of the human body is comprised. Chinese healers have long been aware of the human body’s energy grid, matrix or subtle-energy meridians, as it is variously known, and have mapped them extensively, and also learned how to fix damaged meridians with acupressure, acupuncture, homeopathic remedies and herbs... while Western scientists have simply scoffed.
“David and Yin’s demonstration of microscopic clusters in water is groundbreaking and revolutionary. I had the privilege of testing some of the earliest clustered water and found statistically significant improvement in basic immune function. Their further refined products are even more exciting.”
— C. Norman Shealy, MD, PhD
President, Holos Institute of Health, Inc.
Professor Emeritus of Energy Medicine,
Holos University Graduate Seminary
Founding President, American Holistic Medical Association
Double Helix Water — What it is and How It Works?
Let’s begin with what it’s not. You may have heard of Kangen water or structured water, Ellis water with the angles of its molecular bonds changed, distilled or de-ionized water or energy-infused water. Double Helix Water is none of these.
Double Helix Water isn’t treated in any such way. Instead it is made by applying electrical pressure that surrounds a charged particle to convert ultra-pure water into stable water clusters, creating millions of stable water complexes that have a 7.0 ph and no electrical conductivity. These solid state water clusters behave entirely different from ice, liquid water or water vapor. It is a fourth phase of water, where the space doesn’t change as the temperature changes. It defies the historical classification of water.
Double Helix Water is composed of stable water clusters that, when present in water, combine into Double Helix structures, similar in shape to DNA. These clusters can form the "wiring" of subtle energy meridians along which qi (chi) energy moves in the body. Also, these clusters help DNA, cell membranes and immune cells to function optimally.
You might wonder why this phase of water has never been discovered before?
- The fact is, it couldn’t have been found without the advent of the Atomic Force Microscope, which can view the world of atoms.
- To further complicate the matter, finding this tiny particle in a drop of water is like finding one blade of grass that’s being swirled around in a tornado.
As the researchers began photographing this stable water cluster, they saw it attach to a bacterium and cause it to die. (Black and White Photo)
Because of this phenomenon, Dr Benjamin Bonavida did a series of studies at UCLA where they first looked at any possible effect of Stable Water Clusters on the Immune System. To read an explanation of that first study click here.
Current research indicates that the stable water cluster in Double Helix Water somehow exerts its effects at the gene level.
If this is correct it could be said that it helps the DNA perform the job it’s intended to do. Double Helix Water is likely the most natural product ever found. It enhances and supports life and it tastes just like water!
How Double Helix Water Works
In order to be truly healthy, we need to not only look at a problem or sickness on the outside but we need to peel back layers and layers and go deep inside the body to find the root causes.
- We need to heal from the inside out.
- Illness is never simply one discrete process or dysfunction.
- It is a bundle—a patient’s whole life, from genetics to beliefs and how those influences are layered to create the thing we call disease
- Fortunately for us, the body knows how to heal if we remove the impediments and provide the body with the proper tools and necessities it needs.
Start at the Foundation – The Cellular Level and Double Helix Water
The nature of water is to create a dipole with a positive and negative region and 8 of these dipoles stack in a concerted structure that accentuates the regions. This robust crystal of water can behave like an electrical buffer, attaching to ions long enough to separate them and allow more stable water clusters to interact.
The effects are two-fold:
- When a cell is unhealthy, only limited nutrients are able to penetrate the cell and only partial waste (toxins) exit, leaving the cell lacking necessary nutrients and holding excess toxins.
- When a cell is healthy, all necessary nutrients penetrate into the cell and all waste (toxins) leave the cell, keeping the cell healthy and functioning properly.
Unhealthy Cell

Healthy Cell

A cell membrane’s job is to protect the cell from its surroundings. The cell membrane is selectively permeable and able to regulate what enters and exits the cell.
Permeability depends mainly on the electrical charge and polarity of the molecule. If the cell membrane’s voltage potential is too low, the cell will not function correctly due to the cells permeability being compromised - resulting in insufficient nutrients entering through the cell walls and not enough waste (toxins) properly exiting the cell. This results in a toxic and unhealthy cell.
Double Helix Water normalizes cell membrane voltage potential, which in return regulates proper cell function in regard to intaking nutrients and expelling toxins.
Proper cell function helps unhealthy cells to become healthy again and work at their optimal level.
It is all about nutrition and detoxification when it comes to the body’s approximately 73 trillion cells that require clean air, water, and essential nutrients. If nutrients don't get and toxins don't get out, there is literally no way to improve cellular health. That is why Double Helix Water can make a huge difference... it corrects the subtle eneries of the body, enabling cells to become healthy.
Thousands of infrared images have been taken and analyzed during the research into Double Helix Water and how it affects health
The thermograph images shown below show the difference in tissue temperature after only 15 minutes following ingestion of double helix water, showing its ability to rapidly normalize energy flow.

In thermal imaging, the body temperature is measured to detect increased areas of temperature throughout the body. These elevated temperatures are generally perceived as localized inflammation. Using this information a doctor or integrative professional is able to see and diagnose conditions of individual organs and body parts, based on the measured level of inflammation. As an interesting side note, practitioners practicing oriental medicine are frequently able to observe areas of inflammation coinciding with acupoints. Whereas chiropractors and reflexologists similarly are able to correlate inflammation with misaligned skeletal structure or reflex points needing attention.

These are then used in their diagnosis and treatment of various organs, tissues, and bones along the acupoints.
Regardless of the theory used to diagnose, one fact remains undeniable: In many instances when Double Helix Water is used, and scientific measurements are taken, a rapid temporary normalization of body temperatures is observed in afflicted areas. Long term use has often resulted in a long-lasting return to healthy body temperature.

Fifteen minutes after drinking Double Helix Water, the inflamed and affected areas show a considerable improvement.

The thermal images of this subject shows what could be inflammation in the lower legs, and the ankles. After drinking Double Helix Water, these areas seem to progress to a healthier state. Double Helix Water is redefining health and the body’s role in healing, to find out how read The relationship of cellular health and Double Helix Water.
Live Blood Analysis - Double Helix Water
- The before picture (on the left) shows irregularly shaped red blood cells that are ‘stacked’ together.
- Also, the white shaded areas in the center of the cells are indications of weak and deflated unhealthy red blood cells. The primary job of red blood cells is to transport oxygen throughout the body.
- When they can’t float freely, due to being stacked together, they can’t perform this job properly which can result in illness and disease.
- The after picture (on the right) was taken just 20 minutes after drinking 3 drops of Double Helix Water diluted in Distilled water. As you can see, the red blood cells have taken on a more consistent round, plump appearance and they are no longer stuck together; they are now moving freely.
- The white shaded area in the center of the cells which indicate weak and deflated cells have also decreased dramatically.
Double Helix Water Consumption Appears to Have An Optimizing (or Boosting) Effect Upon the Immune System
- Studies with Double Helix Water, from the very first study, done by an outside laboratory, overseen by one of the world’s leading experts on immunology, show that Double Helix Water produces a significant immune boosting response.
- Higher doses produced faster results.
- Double Helix dosing, optimum timing varies, although the earliest drop off observed in tests so far are after 8 hours intervals.
First Study Showing a Boosting Effect in Regard to Cytokine Production Resulting From Double Helix Water Consumption
The first study on the health benefits and immune support of Double Helix Water was done by B. Bonavida, Ph.D., Professor at UCLA and notable for his work in Microbiology, Immunology & Molecular Genetics, and author of over a dozen scientific books on these subjects and many more scientific papers — a heavy weight when it comes to research.
The results of this very first study were so startling, some found it hard to credit at the time. Even though the study was done by an independent laboratory and headed by Professor B. Bonavida, Ph.D. who is otherwise considered a prominent and meticulous researcher.
The samples of Double Helix Water produced such a high immune response during testing it was thought that the samples had been contaminated by some drug or other factor. This was tested for and found not to be the case.
Notes regarding this study:
- Placebo one and two are samples of regular water. One provided by the laboratory doing testing, the other by the company.
- Also, two separate batches of stable water clusters (Double Helix Water) were tested.
- All results seen in testing were purely due to Double Helix Water
Second Study Showing a Boosting Effect in Regard to Boosting of Interleukin Production Resulting From Double Helix Water Consumption
The result of this second study done with Double Helix Water regarding Interleukin 6 production also showed a large immune system boost.
- Placebo 1 and 2 are both samples of normal water provided by different sources.
- As can be seen the placebos (water) did not produce any reaction at all.
- Stable water clusters (Double Helix Water) on the other hand produced a massive reaction in this test.
- IL-6 is an interleukin that acts as both a pro-inflammatory cytokine and an anti-inflammatory myokine.
Immune Boosting Response Increases with Increasing Dosage of Double Helix Water
Quantity of Double Helix Water shows an increasing boost in production of Cytokine TNF-a with an increased dosage of Double Helix Water, suggesting more is better.
- One of the key question that remains to a degree unresolved is the exact dosage of Double Helix Water.
- The normal dosage (recommended on the bottle of 3 drops twice per day) is fine for most minor issues. In some cases, however, medical practitioners have used much higher quantities for more serious issues. This study shows that it is likely possible to accelerate desired results by increasing the dosage. We have received anecdotal reports that this is true from highly qualified medical practitioners. However, no rigorous study has been done to allow for such a recommendation to be made at this time. Also, one would want to be aware of possible herxheimers or detox reactions. Later studies show that in addition to immune response, Double Helix Water assists in moving both nutrition and intracellular waste across the cell membrane.
How Often Should Double Helix Water Doses Be Repeated?
There is a lot more information that needs to be gathered on this subject. What we can however say is that during the original study, time tables were drawn up looking at various immune responses. Ideal times vary depending on what component of the immune system one is looking at. Our current best estimate is every 8 to 12 hours.
Some immune molecules keep building after a first dose and some start diminishing after eight hours as shown in these two graphs:
Autism Research and Double Helix Water
Autism understanding and treatment is still in its early stages. Only a few years ago, autism was thought to be caused primarily due to genetic reasons, today it is understood that genetics play the lesser role and that autism is largely attributable to environmental reasons. The information that follows shares studies done with Double Helix Water. It is by no means conclusive and is offered merely as educational material and starting points for contemplating further research.
Before and After Images of Autistic Individuals Taking Double Helix Water
- White is the hottest followed by red, then orange and yellow. Each of these hotter areas, potentially indicate an area of inflammation.
- The images above represent a side by side before and after the administration of Double Helix Water, with a time span of only 20 minutes.
- As can be seen there is a notable change in the general body temperature. Continued use of Double Helix Water over time has shown the stabilization of this effect.
- Along with this stabilization, improvement of the subjects autistic symptoms have been reported.
Other studies show similar results. They indicate improvements in the various biological systems after the patient has been administered Double Helix Water for some length of time.
- Double Helix Water, therefore deserve much closer scrutiny in the exploration of a resolution to autism. Initial studies show a larger incidence of change and improvement than any product currently available in the treatment of autism.
- Realizing the common thread between the medical conditions and broad range of symptoms woven through autism, D & Y Laboratories initiated an investigation of Double Helix Water and its effect on autism several years ago.
- The results were both promising and startling, as can be seen in the thermal images, which represents only 20 minutes of difference in time.
- When autistic children were examined through biothermal imaging far higher temperatures than normal were detected in locations of vital bodily systems. The treatment, which consisted of administering Double Helix Water, showed impressive changes in the large majority of cases.
Results after 6 weeks of Double Helix Water treatment
Here are three before and after images of a 2.5 year old boy who had severe health and behavior issues.
- Since birth he required suppositories to excrete.
- He showed little interest in food, seemed addicted to milk and was in the 25th percentile of height and weight in comparison with other children his age.
- He had problems sleeping, exhibited excessive crying and, had a fear of swings, slides and baby rides. – The top row of images are from his first visit.
- The second row images taken 6 weeks after taking Double Helix Water daily.
- The child no longer needed a suppository to excrete, exhibited less crying and tantrums, and had greatly improved social contact with his grandparents and others, among other dramatic changes.
- The child continued the Double Helix Water program. Now four years old, his health continues to improve, and he has advanced in his reading, math, physical, social and communication skills.
- He is now in the 50th percentile of children his age in height and weight, and continues to thrive. It is quite possible that early intervention stopped what may have become a steady decline in health and social skills.
Twin Teenagers and Double Helix Water
Fraternal twin boys now age 17. One was profoundly autistic and the other diagnosed as severely autistic. Their parents tried everything including: doctors, behavior interventionists, HBOT treatments, nutritionists, neurologists, neuroSPECT scans, EEGs, psychiatrists, drugs, etc. Untold sums of money and effort was spent that wiped their parents out financially. Nothing helped. When they reached puberty it only got worse. The parents found out about one of our early Double Helix Water Autism studies and enrolled the twins.
With Double Helix Water They Started To Improve
- By the 4th to 5th months there was significant change: Increase in speech, awareness and cognition, better eye contact, increased sleep, significantly reduced anger and aggression.
- Their teachers reported significant improvement in academics and communication in both twins.
- One of them advanced five academic years in one year.
Categories Measured in Study for Twin # 1:
- Digestive systems, eating and drinking
- Bowel movement, urine
- Body movement, repetitions, OCD
- Sleeping and waking
- Communication of needs, following directions
- Language
- Nonverbal: eye-contact, facial expressions, ticks, postures
- Social skills, social interactions per relationship
- Attention span or focus
- Ability to attend to academic studies
Categories Measured in Study for Twin # 1:
- Digestive systems, eating and drinking
- Bowel movement, urine
- Body movement, repetitions, OCD
- Sleeping and waking
- Communication of needs, following directions
- Language
- Nonverbal: eye-contact, facial expressions, ticks, postures
- Social skills, social interactions per relationship
- Attention span or focus
- Ability to attend to academic studies
Sports Performance with Double Helix Water
Have you experienced aching joints, sore muscles, a stiff back and limbs or other sports related issues? Or are you currently trying to recover from:
- Tendonitis: Inflammation of the tendon connecting muscle to bone.
- Strain: Over-stretch/over-use of a muscle.
- Sprain: Over-stretching a ligament connecting two bones.
- Bursitis: Inflammation of the bursa sack which serves as padding between a muscle and bone.
- Avulsion: Complete tearing of a muscle. Typically along the junction between the muscle and its tendon.
- Contusion: Bruising caused by impact.
- Fracture: Breakage of a bone. Can be complete, partial, or from compression.
If you are affected by any of the above conditions you may want to try Double Helix Water Cream and Double Helix Water in order to boost recovery times.
Double Helix Water moves the negative energy out of an injured energy and the positive energy in. The result is much more rapid healing and recovery.

Ashley Todd CrossFit
“Approximately 2 weeks after I started drinking Double Helix Water I noticed a significant improvement in right shoulder pain I have been battling for over a year. My shoulder is now pain free. I have also noticed a significant improvement in sleep quality. Fast recovery is crucial in the sport of CrossFit, and even more important as an older athlete in the sport.
I am training harder, feeling good, and would recommend it to anyone looking to support their fitness goals.”
Ashleigh Todd — Top 200 CrossFit Athlete In the World (Women’s Division 35-39)
Jen Rhines US Olympian
“Taking the double helix water has been a part of my daily routine for the past six months.
After recovering from an injury that forced me out of the 2012 US Olympic Trials I’m back in top form.
As I’ve worked back into shape over the past months I’ve been feeling great and recovering from hard training as quickly as I was 10 years ago.
As a 38 year old professional runner I’m routinely competing against athletes 10 to 15 years my junior so it’s great to feel youthful and competitive again!”
Jen Rhines — 3 time US Olympian


David Prince Two-Time Paralympian, Team USA
"In my athletic career, I have been drawn to the science behind my body; the mechanics of the human body, how it uses energy, the bodies ability to recover, and so on. Being a unilateral amputee adds a new level to understanding the science behind my how my body moves, uses energy, and recovers from the training I put it through. What I love about Double Helix Water the most is all the research behind it. I could spend hours reading all the amazing science behind how Double Helix Water works. This isn’t some potion making promises it can’t deliver. I rely on Double Helix Water to support my body as I put it through rigorous training on the track and hours in the gym. If I forget to add it to my hydration, I notice. I am not a young sprinter anymore; in fact I’m usually the oldest on the track but I know using Double Helix Water gives me the edge I need to get me on that podium."
David Prince — Two-time Paralympian & Unilateral Sprinter for Team USA in Track and Field. Paralympic Medalist.
Bob Haviland
- AS in Physical Therapy
- MS in Exercise Physiology/Sports Performance & Rehab Science
- C.S.C.S (certified strength/conditioning specialist)
- C.E.S (corrective exercise specialist)
- C.N.C (certified nutritional consultant)
"I am extremely excited and honored to be aligned with Double Helix Water. I have definitely noticed an improvement in my focus, concentration and overall endurance and intensity since using these products."
Bob Haviland —
USAT All-American Triathlete and 2 time World Championship Iron-man Hawaii Qualifier and Iron man Florida finisher.

Dr. Bob Rich
Wounded Warrior Project, Race Across America 2017
"Thank you for supporting me in my Race Across America Team Honor Warriors event! I also want to give you feedback on my experience during the race using the Double Helix Water.
On the first two and half days through the California, Arizona and Utah desert, temperatures ranged from 114 degree high’s to 40 degree low’s. The desert is always a major obstacle for many of the riders and is usually the place where most drop out due to the intense heat and terrain. Even while crossing Kansas, the temperatures were 108-110 degrees. Working on little to no sleep for the 3,000 + mile crossing also presents more stress for the body to deal with.
My protocol for using Double Helix Water was to take 4 bottles on the first two days then 3 bottles per day for the remaining 6 days. I am pleased to report that I never experienced sore muscles or cramps of any kind during the 8 plus days of effort!
I have used double helix water for many years to help with inflammation and speeding up the recovery process, always with exceptional results! I highly recommend Double Helix Water to my clients and will continue to use it for myself! Thanks again for your support and for following my team’s progress as we crossed the U.S." -- B. R.

Who Ought To Be Consuming Double Helix Water?
Easy answer - anyone who has been damaged by environmental toxins, surgeries or accidents. Meridians are damaged by such things and repairing them will give the body the facility to function better once the stable water clusters repair or fill in the gaps of those damaged meridians.
Double Helix Water Protocols of Use
Easy answer - anyone who has been damaged by environmental toxins, surgeries or accidents. Meridians are damaged by such things and repairing them will give the body the facility to function better once the stable water clusters repair or fill in the gaps of those damaged meridians.
Double Helix Water Ordering
Our Price: $62.95 Quantity Discounts Available at 3, 6 and 9 units.
Double Helix Water
|
||||||||||||||
Comparative Retail Price: $26.95
Our Price: $14.95
Theoretical physicist Dr. Shui-yin Lo, and his engineering research partner, David Gann, present their groundbreaking research on a previously undiscovered molecular phase of water in their book, Double-Helix Water: Has the 200-Year-Old Mystery of Homeopathy Been Solved?
Fifteen years in the making, this pioneering work is a manual of their research that guides the reader through the duo’s work and how a newly discovered phase of water may be the key to many of the body’s inherent healing properties. The discovery of this particle has begun to unravel the mystery behind the differences between allopathic and homeopathic medicine as we know it.
Dr. Shui-yin Lo received his doctorate in theoretical physics from the prestigious University of Chicago. The Foreword to this book was written by C. Norman Shealy, MD, PhD, a neurosurgeon who founded the American Holistic Medical Association.
Paperback, 316 Pages
Videos about Double Helix Water
We disclaim any claims (if there are any) made in these videos. They are for information, education, enlightenment and entertainment only.

